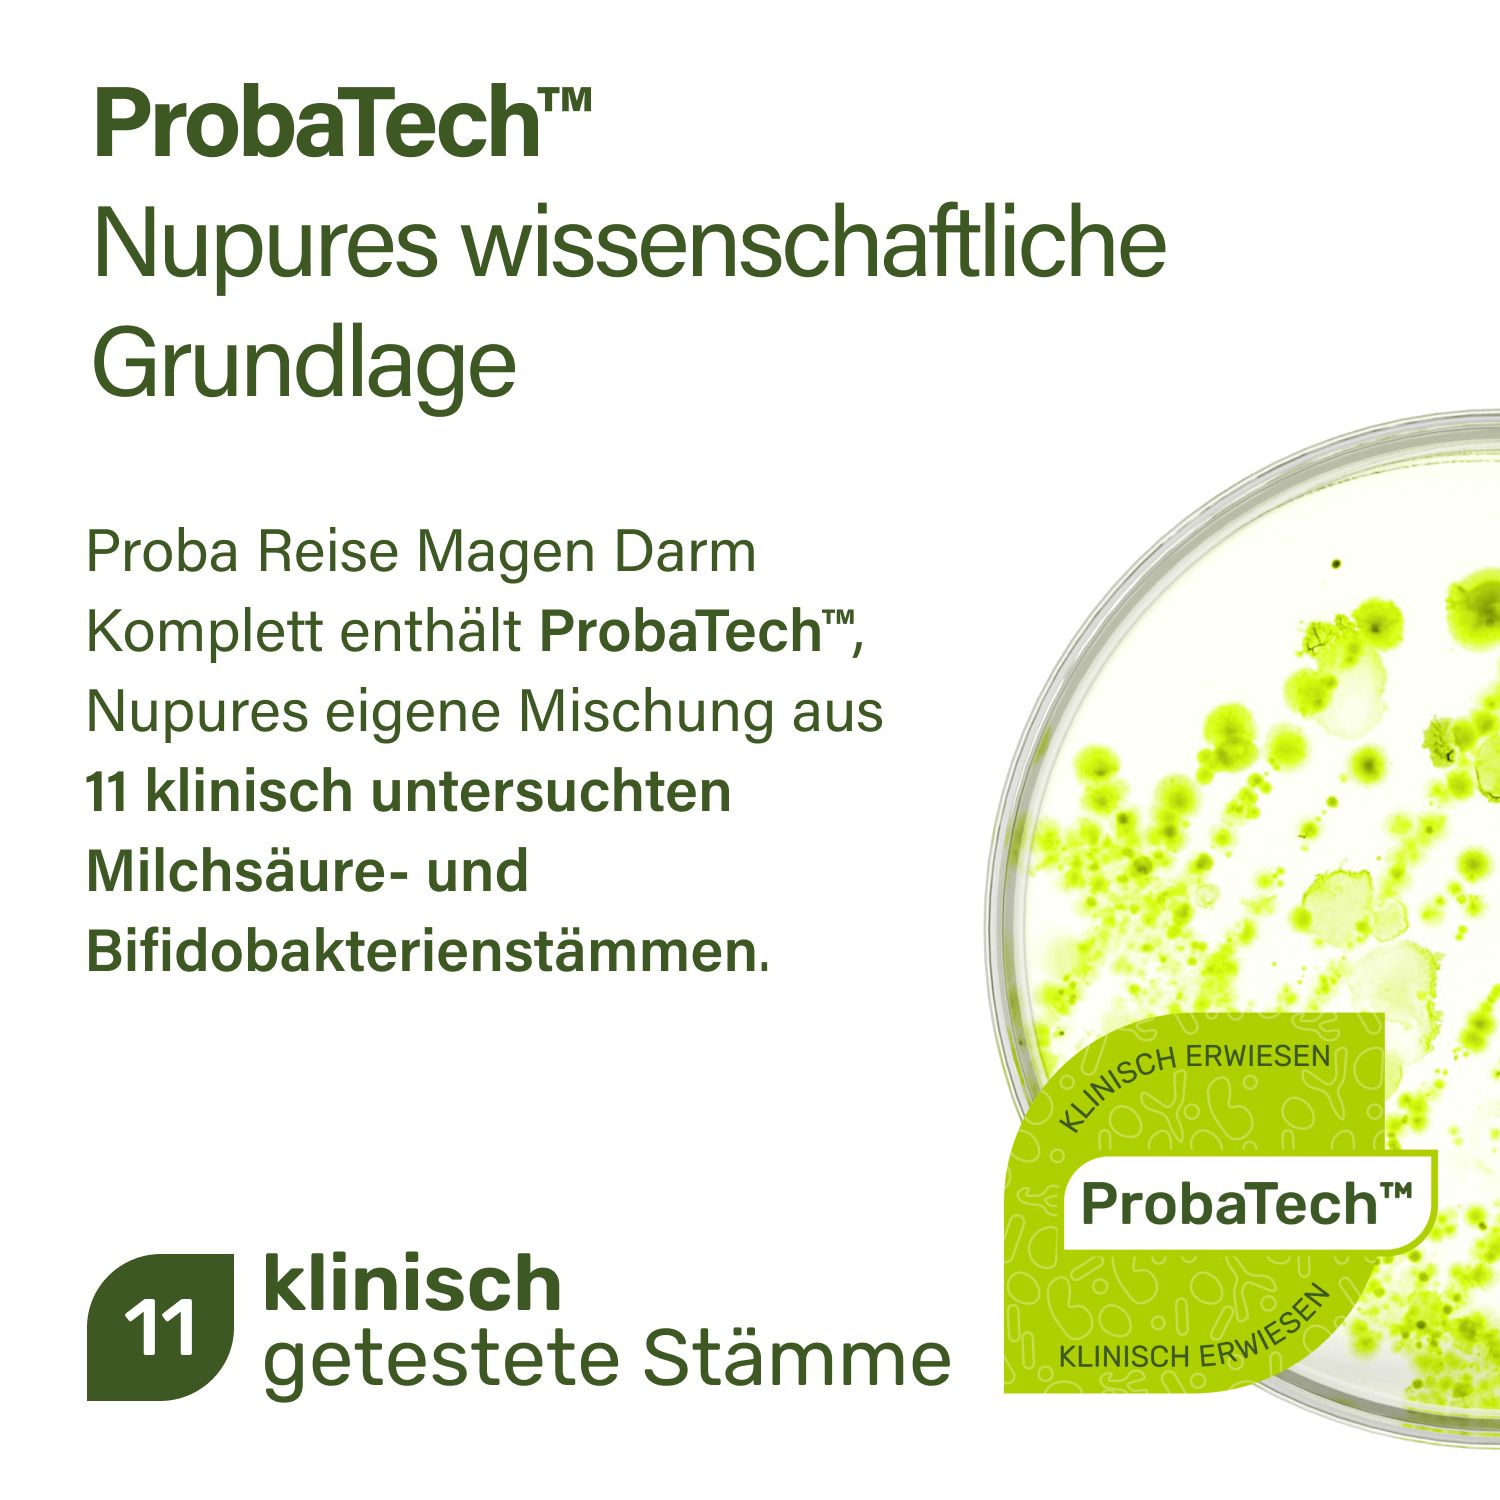
Nupure Proba Reise Magen Darm Komplett Kapseln – Mit 11 Milchsäurebakterienkulturen (ProbaTech™), Pylopass™ und Ingwerextrakt

Shop-Apotheke Service B.V.
Nupure Proba Reise Magen Darm Komplett Kapseln – Mit...
Nahrungsergänzungsmittel sind kein Ersatz für eine ausgewogene und abwechslungsreiche Ernährung und eine gesunde Lebensweise. Nupure Proba Reise Magen Darm Komplett ist ein Nahrungsergänzungsmittel in Kapselform mit ProbaTech™, Nupures eigener Mischung aus 11 Milchsäurebakterienkulturen, Pylopass™ (Lactobacillus reuteri DSM 17648, inaktiviert) und Ingwerextrakt. Die Einnahme erfolgt 1x täglich mit ausreichend Flüssigkeit. Die Rezeptur vereint bakterielle Kulturen mit einer wärmeinaktivierten Bakterienkultur sowie pflanzlichem Ingwerextrakt in einer veganen Kapsel. Das Produkt ist frei von Zucker, Gluten und künstlichen Zusatzstoffen. Warum Proba Reise Magen Darm Komplett? ProbaTech™ – Nupures eigene Mischung aus 11 Milchsäurebakterienkulturen Pylopass™ (wärmeinaktivierte Bakterienkultur) Mit Ingwerextrakt 1 Kapsel täglich Vegan, glutenfrei, ohne Zucker Hergestellt in der EU Zutat...
Qualitätssiegel




Artikelnummer:
44415013750Lieferung / Leistung in:
E-Mail:
kontakt@shop-apotheke.comNachhaltigkeit